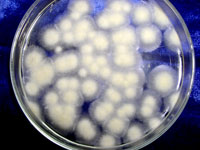

|
Biomasa, materia primă pentru biocombustibili
Biomasa contribuie cu 14% la consumul mondial de energie primară, iar pentru trei sferturi din populaţia globului care trăieşte în ţările în curs de dezvoltare aceasta reprezintă cea mai importantă sursă de energie. La nivelul Uniunii Europene se preconizează crearea a peste 300.000 de noi locuri de muncă în mediul rural, tocmai prin exploatarea biomasei. În prezent, în UE, 4% din necesarul de energie este asigurat din biomasă. |
|

|
|
Se caută surse regenerabile
Agenţia Internaţională pentru Energie estimează că în Europa, resursele de petrol se vor epuiza în 40 de ani, cele de gaze naturale în 60 de ani, iar cele de cărbune în 200 de ani, lucru care s-ar traduce prin faptul că, peste aproximativ 20 de ani, Europa va fi nevoită să importe 70 la sută din necesarul de energie. Ca urmare a acestui fapt, statele uniunii au fost nevoite să găsească surse regenerabile. Uniunea Europeană îşi doreşte ca, până în anul 2020, 20% din consumul de energie al statelor comunitare să fie asigurat din surse regenerabile. |
|

O biorafinărie în Hastings, Nebraska - transformă anual 0,6 Mtone cereale în 250 milioane litri etanol |
|
Ce sunt biocombustibilii?
Criza mondială de energie din ultimul timp a pus pe jar comunitatea ştiinţifică internaţională. Preţul ţiţeiului este tot mai greu de controlat. De aceea, trebuie căutate noi metode de a obţine combustibili “pe cale naturală”. Se pare că soluţia cea mai bună o reprezintă înlocuirea combustibililor convenţionali, fosili cu combustibili obţinuţi din surse regenerabile. Aceştia se numesc biocombustibili şi deja s-a început procesul de substituire treptată a combustibililor convenţionali cu acest nou tip de carburant. Din ce se pot obţin biocombustibilii? După cum o spune şi definiţia lor – din resurse regenerabile, adică dintr-o materie primă care poate fi refăcută permanent. O sursă permanentă de materie energetică o reprezintă plantele care conţin glucide sau poliglucide care înmagazinează energie. O astfel de plantă este porumbul. Orice crescător de animale ştie că porumbul conţine mult amidon, care este transformat de animalul care îl consumă în energie, care, dacă depăşeşte necesităţile energetice ale organismului este stocată sub formă de ţesut adipos. Amidonul poate fi transformat însă cu ajutorul enzimelor în glucoză, care poate fi fermentată cu ajutorul microorganismelor în etanol. Iată, deci o altă modalitate de a exploata energia înmagazinată în porumb, şi anume transformarea ei în etanol, care poate fi amestecat cu benzina şi ars în motoare. Pe lângă porumb, se mai folosesc şi alte produse vegetale pentru obţinerea de biocombustibili: sfecla de zahăr, soia, rapiţa, sau chiar uleiurile rezultate de la restaurante după prăjirea alimentelor. Grăsimile animale reprezintă o altă sursă regenerabilă de biocombustibili. |
|
Diferite tipuri de biocombustibili:
Biocombustibil |
Ce este? |
Argumente Pro |
Argumente Contra |
Etanol din biomasă agricolă |
Alcool obţinut prin fermentarea cerealelor, plantelor tehnice şi altor surse vegetale |
Combustibil cu cifră octanică mare şi emisii reduse de gaze cu efect de seră |
Dificultăţi în transportul prin conducte, consumă cantităţi mari de biomasă agricolă alimentară sau furajeră |
Etanol din lignoceluloză |
Alcool obţinut prin conversia biomasei lignocelulozice la glucide fermentescibile urmată de fermentarea acestora la etanol |
Combustibil cu cifră octanică mare şi emisii reduse de gaze cu efect de seră. Nu utilizează materii prime alimentare sau furajere |
Dificultăţi în transportul prin conducte. Este mai scump decât etanolul din cereale. |
Biogaz |
Amestec de gaze ţn care predomină metanul, obţinut prin fermentarea anaerobă a gunoiului sau altor deşeuri sau subproduse agricole, menajere sau industriale |
Materia primă este nevaloroasă, rol important în managementul deşeurilor. Poate fi o sursă de energie în comunităţi rurale, sau zone sărace ale globului. |
Este greu de lichefiat şi de aceea nu poate fi folosit în transporturi. Comoziţia lui este heterogenă, în funcţie de materia primă şi tehnologie. |
Biodiesel |
Un carburant asemănător motorinei, obţinut din uleiuri vegetale |
Reduce emisiile şi este lubrifiant pentru motoare |
Dificultăţi în transportul prin conducte. Nu este agreat de toţi constructorii de motoare şi automobile |
Motorină regenerabilă |
Un carburant asemănător motorinei, obţinut din grăsimi vegetale şi hidrocarburi |
Corespunde standardelor pentru motorină cu conţinut foarte scăzut de sulf, adaosul de grăsimi animale îmbunătăţeşte proprietăţile de igniţie; poate fi transportat prin conducte |
Emisiile sunt mai ridicate ca în cazul biodieselului |
Biobutanol |
Combustibil alcoolic, asemănător etanolului |
Mai uşor de transportat, mai puţin coroziv în conducte decât etanolul |
Nu se produce încă la capacitate mare |
|
|
Intrări:
Cereale
Melasă
Coceni
B.L.C.
Rumeguş
Borhot
Plante energetice
Deşeuri |
|
Ieşiri:
Alcool
CO2
Glicerol
Sustanţe chimice
Subst. solubile
Drojdie
Aditivi furajeri |
Biorafinărie |
|
|
Etanol din biomasă lignocelulozică
Subprodusele sau deşeurile rezultate din activităţi agricole sau industriale şi care conţin celuloză (paie, coceni, hârtie etc) reprezintă o sursă importantă de energie nevalorificată corespunzător. Deşeurile celulozice pot fi hidrolizate la glucide simple, fermentescibile (glucoză, celobioză, xiloză etc), care pot fi fermentate la etanol, butanol, sau alţi compuşi care pot fi carburanţi sau materie primă pentru industria chimică. Pentru a fi viabil din punct de vedere economic, costul de producţie a etanolului din biomasă lignocelulozică, trebuie să fie competitiv cu ceilaţi biocombustibili. În proiectul de cercetare cu titlul Conversia biomasei lignocelulozice la etanol prin hidroliza si fermentare simultana, vom încerca să elaborăm o tehnologie ieftină de conversie a biomasei lignocelulozice la etanol. Procedeul presupune prehidroliza biomasei lignocelulozice, urmată de o etapă comună de zaharificare enzimatică a celulozei şi cofermentarea glucidelor rezultate la etanol. Astfel, glucoza rezultată în urma hidrolizei celulozei va fi imediat transformată în etanol, deci nu va mai inhiba activitatea celulazelor. Biomasa lignocelulozică este mai întâi pretratată şi detoxifiată, eliberând componentele glucidice. Tratarea cu hidroxid de calciu va înlătura din faza lichidă compuşii eliberaţi în timpul pretratării, potenţial toxici pentru microorganismul folosit la fermentare. Detoxifierea este aplicată doar fazei lichide. Hidroliza enzimatică (zaharificarea) cuplată cu fermentarea este realizată în condiţii privative de oxigen. În faza de hidroliză se adaugă preparate enzimatice celulozolitice şi se menţine o perioadă de timp la temperatură constantă pentru optimizarea activităţii enzimatice. Microorganismul care va reliza fermentarea glucidelor este mai întâi multiplicat pentru a obţine inoculul. Acesta, împreună cu nutrienţii necesari dezvoltării microorganismului producător de etanol este introdus în fermentator împreună cu suspensia prehidrolizată şi cu enzimele celulozolitice. Amestecul de biomasă pretratată, celulaze şi microorganisme fermentative este adus la o temperatură comună de activitate a enzimei şi a microorganismului. În timpul fermentaţiei, hidroliza celulozei se va face cu o intensitate mică, deoarece temperatura optimă microorganismului este mai mică decât temperatura optimă de activitate celulozolitică. După câteva zile de zaharificare şi fermentare, majoritatea celulozei va fi convertită la etanol. |
|
Biotehnologiile şi biocombustibilii
Biotehnologiile găsesc soluţii acolo unde alte discipline îşi ating limitele, după cum o spune şi definiţia biotehnologiilor, şi anume: aplicarea integrată a cunoştinţelor şi tehnicilor de microbiologie, genetică, biochimie şi inginerie chimică, în scopul de a produce cu ajutorul celulelor microbiene, animale şi vegetale, substanţe utile sau servicii necesare societăţii. Soluţia găsită în acest caz este obţinerea etanolului nu din porumb, ci din biomasă lignocelulozică. Ce este biomasa lignocelulozică? Orice subprodus, deşeu agricol, menajer sau industrial care conţine celuloză. Biomasa lignocelulozică reprezintă o sursă abundentă şi ieftină de resurse energetice regenerabile. De exemplu, reziduurile de trestie de zahăr numite bagase rezultate în urma extracţiei zahărului din trestia de zahăr sunt generate în cantităţi foarte mari în ţări ca Brazilia, Tailanda, India, Hawaii şi sudul SUA. Teoretic, o tonă de bagase uscată poate genera circa 424 litri etanol. Alte produse lignocelulozice care pot fi folosite ca surse de energie pot fi: reziduuri sau subproduse agricole: coceni de porumb, paie de grâu sau orez; reziduuri forestiere; reziduuri din industria de celuloză şi hârtie; plante ierboase energetice. Însă, spre deosebire de amidon, care este un polimer omogen şi uşor de hidrolizat, materia lignocelulozică vegetală conţine celuloză, hemiceluloză, lignină şi alte componente greu de hidrolizat. Toate aceste componente trebuie iniţial tratate chimic şi enzimatic până sunt transformate în zaharuri care pot fi fermentate la alcool. Cu toate că biomasa lignocelulozică este disponibilă în cantităţi foarte mari, provocarea principală pentru a face produsul competitiv din punct de vedere comercial este reducerea costurilor procesului de conversie a biomasei la etanol. Deja sunt câteva proiecte finanţate pentru a produce alcool ieftin din celuloză, în SUA ţelul fiind până în 2010 un cost de producţie de 1,07 USD/galon etanol.
La Facultatea de Zootehnie şi Biotehnologii din cadrul USAMVB Timişoara se fac cercetări în acest sens de câţiva ani. Cercetările efectuate de colectivul de la disciplinele de Microbiologie Industrială şi Tehnologia Produselor de Biosinteză au ca bază Colecţia de Microorganisme Industriale care este gestionată de personalul din cadrul acestor discipline. Această bancă de celule microbiene conţine peste 50 de tulpini de bacterii, drojdii şi fungi de interes industrial şi agricol. Tulpinile sunt conservate atât prin refrigerare, cât şi prin congelare. O parte dintre tulpini sunt modificate genetic, în scopul ameliorării capacităţii productive a unor substanţe biologic active. Cercetările efectuate de acest colectiv, legate de domeniul biocombustibililor includ:
1. Aplicarea metodelor de ameliorare genetică prin selecţie şi mutageneză a drojdiilor folosite în industria alcoolului şi ca probiotice. În urma acestor lucrări au fost obţinute noi tulpini de Saccharomyces cerevisiae din următoarele tipuri morfologice: tulpini de tip rugos, floculant, preferate de producătorii de biomasă proteică furajeră sau de producătorii de bere; şi tulpini de tip neted, nefloculant, care sunt preferate de producătorii de alcool.
2. Ameliorarea genetică prin selecţie şi transformare a microorganismelor producătoare de enzime hidrolitice (proteaze, amilaze, celulaze). În acest scop au fost aplicate metode de:
- transformare directă a unor tulpini de Bacillus subtilis cu ADN cromozomal de la Bacillus globigii, în scopul ameliorării capacităţii de producţie a amilazelor;
- transformare prin electroporare, transformare de protoplaşti şi transformare directă în prezenţă de cationi bivalenţi a unor tulpini de Bacillus licheniformis cu ADN plasmidial în scopul ameliorării capacităţii de producţie a proteazelor.
- de asemenea au fost selecţionate tulpini de Trichoderma viride şi Aspergillus niger producătoare de enzime celulozolitice necesare pretratării enzimatice a biomasei lignocelulozice şi transformarea ei în glucide fermentescibile.
3. Testarea tulpinilor de microorganisme la nivel de laborator şi în bioreactor micropilot în vederea stabilirii capacităţii de biosinteză în condiţii specifice industriale urmată de izolarea produsului de interes din mediul de biosinteză.
|
|
|
Fungi celulozolitici |
Drojdia S. cerevisiae |
Drojdia S. cerevisiae |
Cercetările realizate în acest domeniu vor permite alinierea României la tendinţele actuale ale cercetării ştiinţifice internaţionale în domeniul biotehnologiilor industriale (grey biotechnologies) şi de mediu (green biotechnologies), de asemenea, vor contribui la promovarea biotehnologiilor moderne cu aplicabilitate practică în industria şi agricultura din ţara noastră. Cercetările noastre se încadrează în priorităţile europene de cercetare, şi anume în aria tematică nr. 2, Alimentaţie, agricultură şi biotehnologii, subdomeniul 2.3. Ştiinţele vieţii şi biotehnologii pentru produse şi procese ne-alimentare durabile. |
|
Revizuirea Protocolului de la Kyoto
Toate tarile prezente la conferinta de la Bali, inclusiv SUA, au ajuns la un consens care deschide o fereastra larga pentru un volum mare de lucru, ale carui rezultate vor fi facute publice la Copenhaga, in 2009.
Secretarul general ONU, Ban-Ki Moon, si presedintele Indoneziei au reusit sa convinga tarile participante ca trebuie lansate procesele pentru o mai buna implementare a masurilor de combatere a schimbarilor climatice.
S-a stabilit ca trebuie urmate actiuni pentru prevenirea schimbarilor climatice prin angajamente intre tarile in curs de dezvoltare, prin eficientizarea tehnologiilor, prin cautarea furnizorilor de surse financiare si, nu in ultimul rand, prin crearea unui grup de lucru care va trebui sa stabileasca concret viziunea de dupa anul 2009.
În urma conferintei de la Bali, care s-a incheiat în 15.12. 2007, s-a stabilit de asemenea, ca revizuirea Protocolului de la Kyoto va avea ca scop intarirea sistemelor de implementare a proiectelor necesare, bazandu-se, in acelasi timp, si pe o evaluare mult mai buna a rezultatelor. Se vor crea noi elemente procedurale pentru angajamente intre tarile dezvolate. Trebuie luata in considerare minimizarea efectelor schimbarilor climatice asupra tarilor mici si statelor insulare.
Concret, s-a creat un cadru general in spatele caruia va urma o munca infernala care va stabili ce se va intampla dupa anul 2009.
Desi intelegerea de sambata nu prevede obiective concrete de reducere a emisiilor de gaze cu efect de sera, asa cum a vrut Uniunea Europeana, oficialii au salutat reusita demararii negocierilor pentru acordul post-Kyoto. |
|